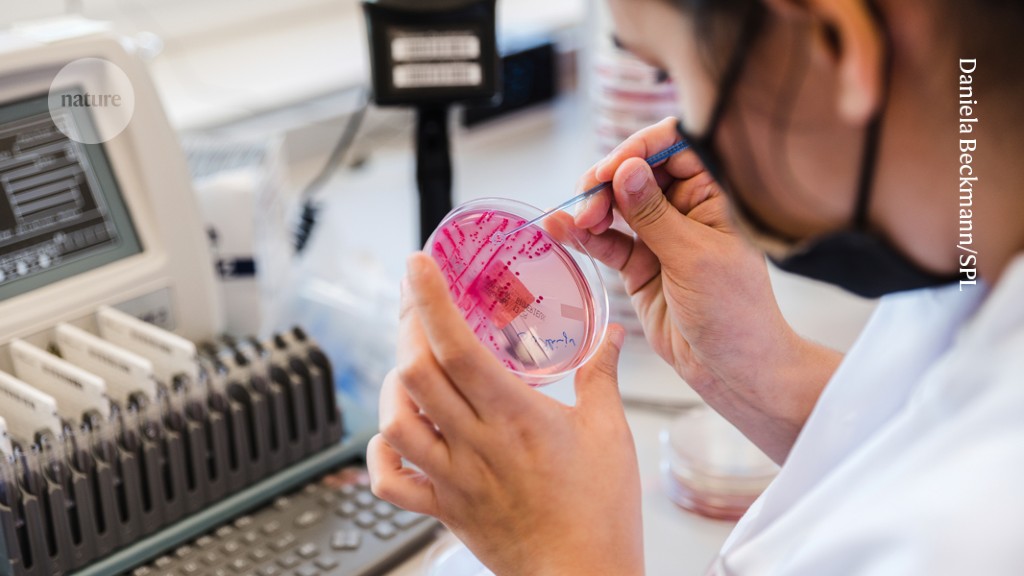
Featured image for "Advancing Open Science: Momentum Grows for Laboratory Material Sharing"

Germany's PubMed Rival Sparks Healthy Competition
Germany's National Library of Medicine is developing an alternative to PubMed to promote digital sovereignty and resilience in scientific communication, sparking debate about the risks of reliance on a single global platform and emphasizing the importance of diverse, transparent knowledge systems for scientific progress.